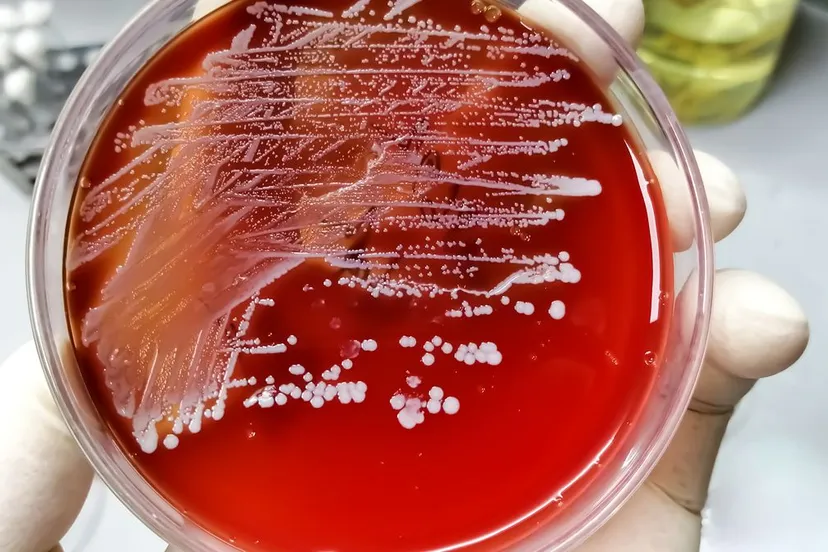
staphylococcus petrischaaltje

Save the date: nieuwjaarsbijeenkomst gemeente Sittard-Geleen
19 nov 2024, 14:00 • Gemeente

Gemeente Sittard-Geleen
Het einde van het jaar 2024 nadert nu met rasse schreden, nog een week of zes en het nieuwe jaar begint.
Ook in 2025 nodigt de Gemeente Sittard-Geleen-Born u uit voor de nieuwjaarsbijeenkomst. Die wordt op dinsdag 7 januari vanaf 18:00 uur gehouden in het Toon Hermans Theater aan de Monseigneur Claessensstraat 2 in Sittard. Zet maar alvast in uw agenda!
Loading articles...
Loading